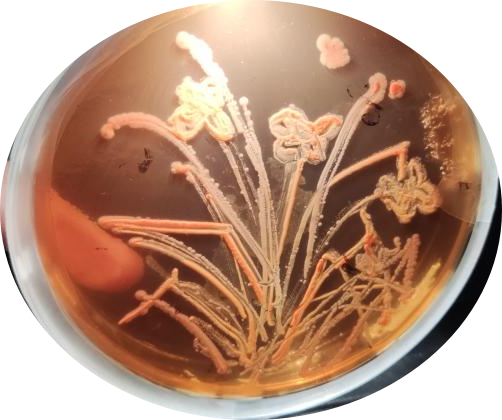
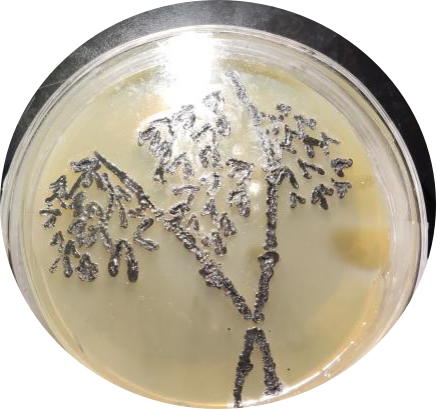
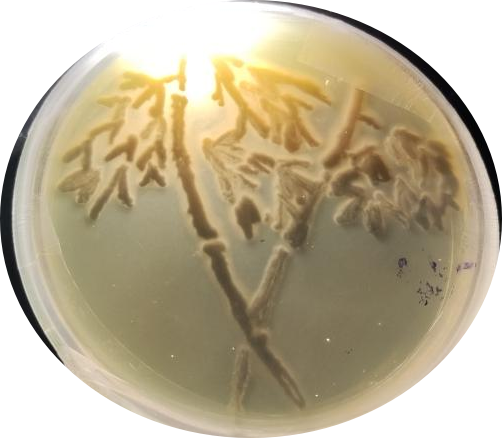

(学生通讯员 龚文磊 谢莉莉)为加强劳动教育和全面贯彻党的教育方针、培养全面发展人才的要求,并充分挖掘大学生的实践能力和创新能力,4月17日至4月28日,我院开展为期两周的劳动实践周系列活动,我院20级、21级、22级全体学生参加此次活动。
(一)实验室绿色化、安全化改造活动
为营造良好的实验环境,提高同学们爱护实验室的意识,4月17日上午,我院于理工楼实验室组织开展实验室绿色化、安全化改造活动。活动期间,老师给同学们讲解关于绿色化改造和安全化改造的重要性,帮助同学们树立实验室绿色理念和环保意识,养成良好实验操作行为习惯,强化实验室安全意识等。同学们有序分配改造任务,并积极参与改造和付出实际行动。此次活动的开展,不仅极大地锻炼了同学们的实践能力,以劳增智促进学生全面发展,还为我院高素质人才培养工作起到积极助推作用。

(二)师范生班主任能力班级赛赛前动员会
为进一步落实立德树人根本任务,适应基础教育改革发展对师资培养的需求,围绕“践行师德、学会教学、学会育人,学会发展”四个维度,4月17日上午,我院于二教楼教室组织召开2023年师范生班主任能力班级赛赛前动员会,会议由我院教学与科研办公室李砚老师主持。李砚向21化学班的同学们详细介绍师范生班主任能力班级赛的规则及要求,同时深入分析目前我国的教师行业现状和前景,强调作为师范生在今后的教学工作中班主任工作的成长作用。本次会议的召开,不仅有助于提升师范生班主任专业能力水平,还展现出我院对师范生培养的高度重视,更有利于我校今后向社会输出优秀的师范生人才。

(三)实验室安全微视频大赛
为规范学生实验操作,提高实验安全意识,4月18日上午,我院于理工楼实验室开展实验安全微视频大赛,大赛由我院教师彭素红担任指导老师,其他专业老师担任评委,22级应用化学班全体学生参加大赛。比赛伊始,彭素红为同学们讲解本次活动的内涵及比赛的规则,并提出以视频的形式展示最终成果。视频拍摄过程中,每组同学通过不同的角度来表达对实验室安全这一主题的见解。随后彭素红根据每组视频的新颖点和不足之处提出相应意见及改进建议。此次比赛的开展,不仅进一步提高同学们对实验室安全的重视程度,也提升了同学们拍摄与剪辑视频的创作能力,还为我院营造良好的实验室安全文化氛围奠定了基础。


(四)企业见习活动
为促进同学们灵活运用专业理论知识与实践活动相结合,4月16日至19日,我院根据专业特点组织20食品质量与安全、20生物工程、20制药工程班级学生赴赴(上高)旺旺集团、江西锦江酒厂及江西百神药业股份有限公司开展一系列见习活动。见习期间,师生一行在企业职工的介绍下了解到企业文化与公司布局,现场观摩企业产品以及生产机器等。参与见习的同学们都仔细聆听并作好笔记,认真学习工作人员分享的专业知识和工作经验,对于有疑惑的地方现场及时向工作人员咨询请教。见习活动的开展,不仅激发在校大学生对专业学习的兴趣,学会对专业知识的合理运用,也进一步推动我院专业建设和人才培养工作顺利进行。



(五)“药物研发过程中的伦理学”知识讲座
4月19日,我院于二教楼教室举行“药物研发过程中的伦理学”知识讲座,我院教师白庆云担任主讲人,21级药学专业全体学生认真聆听此次讲座。白庆云老师详细讲解药物开发与研究的过程与内容,解释关于伦理学的定义,并深入解读医学伦理学的内容、意义以及药物伦理学对于药物的研发与应用的意义。此次讲座的开展既有助于同学们了解新药的研发及上市过程,自觉遵循职业道德准则和义务,又为我院人才培养工作起到助推作用。
(六)校园药用植物野外实践活动
为巩固强化与应用课堂的所学知识,提高药学专业学生辨别药用植物的能力,4月18日至21日,我院于校园内开展为期四天的校园药用植物野外实践活动。实践过程中,我院李君玲、申秀丽、彭秋玲老师系统讲解植物标本的制作学习及野外植物识别考核标准,并强调野外实践活动的相关注意事项。同学们跟随老师们辨认和采摘植物,认真聆听老师的讲课并随时做好笔记。此次实践活动的开展,不仅极大地激发同学们对植物探索的热情,将所学的理论知识与实践活动相结合,也加深同学们对专业知识的了解,更为今后的专业学习打下坚实基础。




(七)厨房的艺术活动
为促进人才培养计划的实施,实现理论知识、实践技能以及生活艺术的有机结合,4月24日上午,我院于理工楼实验室开展厨房的艺术活动。活动由周健作为指导教师,20化学教育班级学生参加。活动的主要内容是通过紫薯在不同酸碱环境下的颜色变化来制作染料,加入各自新奇的创意绘画出鲜艳夺目的作品。随后周建和学生代表对各小组在实验过程中表现和作品进行点评。周健告诉同学们染料与空气中的二氧化碳反应会使颜色发生变化,产生不一样的美,在制作过程中根据需要要注意时间的把握。此次活动的开展,有效的提高了学生的学习趣味并引导其创新想法的发散,同时也增强我院的师生们在食品文化方面的沟通和交流,进一步体现出我校寓教于乐的教学理念。



(八)中等教育专家专题讲座
为增强师范专业学生的专业认知水平,提升职业素养,4月25日上午,我院于二教楼教室举办中等教育专家主题讲座。本次讲座由宜春中学教师陈智华担任主讲人,20级化学教育班级全体同学聆听讲座。讲座中陈智华与同学们分享了自身的从教经历,并从班主任的专业素养、班主任的困惑、班主任的危机等方面展开论述。他提出在“做一名合格班主任”应当熟悉全班学生的思想、学习、生活和健康等情况,并着重强调在走访学生家庭的时要坚持“六必访”原则。此外,陈智华还指出可以适当运用公式和法则来激励学生学习。此次讲座的举办,不仅帮助同学们启发对职业和就业方向的思考,为促进我院为国家培育德才兼备的新时代教育工作者奠定基础,助力我校为国家建设输送高质量技能人才。

(九)电化学图案化设计大赛
为提升学生的专业素养,强化学生对电化学知识的运用与创新,4月25日,我院于二教楼教室举行电化学图案化设计大赛。此次比赛由我院应用化学专业负责人朱凤指导,20级应用化学班级全体同学参加。比赛伊始,同学们自由分组并商量需要设计的图案或者文字,并选择颜色进行勾勒后用电化学的方法进行描摹,使图案成型。比赛时,每位同学都认真投入到小组图案设计的讨论和绘制中,朱凤也在及时解答同学们的疑惑和给出指导性的建议,帮助同学们将理论与实践相结合,利用电化学知识创作出精美的作品。此次大赛的举行,不仅加强应用化学专业学生对专业知识的巩固,还展现出我院教学的多元化、实用化和专业化。

(十)“化学创造美好生活”专题讲座
为让学生认识到生活中化学的重要和美好,4月25日下午,我院于二教楼教室举办“化学创造美好生活”专题讲座。讲座由我院教师邹怀波担任主讲人,22级应用化学班全体同学聆听学习。讲座伊始,邹怀波从介绍生活中常见物品的制作过程入手,指出化学在生活中的普遍性。接着邹怀波对当代人“闻添加剂‘色变’”这一现象发表了自己的观点。他指出在符合国家食品安全规定的前提下,适当的食品添加剂可以延长食物保质期和进行调味等。他强调化学是人类创造美好生活的基石,同时也号召同学们学会利用化学知识提高生活质量。此次讲座的举办,不仅有助于激发同学们的学习热情,还展现出我院对培养学生专业性和多样性的发展的高度重视,更对我校学术气氛的营造具有良好的促进作用。


(十一)化学科普设计大赛
为夯实学生的化学基础知识和基本理论,培养学生的科学精神和科学素养,4月26日,我院于二教楼教室举办化学科普设计大赛,21级应用化学班级全体同学参加本次比赛。比赛期间,在周健老师的悉心指导下,八个参赛组各派出代表按顺序依次上台汇报展示本组的实验成果,其中包括对实验原理的介绍,简述实验步骤,以视频形式展现学生实验过程及其结果。此次比赛的开展,一方面充分激发学生动手实验的积极性,为学生提供互相学习交流的机会;另一方面也体现出我院对培养学生科学素质和创新动手型科技人才的高度重视。


(十二)食品工程伦理讲座
为加深学生对食品工程的认知,提升学生学习工程知识的兴趣,4月26日,我院在20食品质量与安全班级开展工程理论讲座,讲座由食品质量与安全教研室主任李秋红担任主讲。此次讲座从科学伦理的涵义、特点、价值入手,强调了尊重研究对象、对社会后果负责、合理协调相关利益关系、公正进行学术评价四个基本原则。同时讲座结合部分典型事例的分析讲解,提出学术活动中的道德规范准则,生动地诠释养成正确的科学伦理和学术道德的重要性。此次工程伦理讲座的开展,不仅加深同学们对食品工程知识的理解,学会对相关知识的合理应用,还为我院营造出“维护公共利益,恪守工程伦理”的良好氛围。

(十三)化学史中的科学思维挖掘主题活动
为培养应用化学专业学生的化学思维,4月24日至27日,我院于二教楼教室开展化学史中的科学思维挖掘主题活动,本次活动由我院副院长张文彬组织。活动中,张文彬说明活动的详细规则后,同学们以PPT形式对物质发现过程或者化学史上的杰出人物进行有关化学思维的讲述。此次活动的开展,不仅成功激发同学们对化学学习的热情,提升同学们的专业学习能力,还有利于我院今后向社会输送优秀的专业人才。
(十四)食品工程设计大赛
为提升学生的创新思维和实践能力,4月28日,我院于二教楼教室举办食品工程设计大赛。本次比赛由我院食品质量与安全专业负责人叶文峰、食品质量与安全教研室主任李秋红进行指导、点评和打分,20级食品质量与安全班级全体学生参与比拼。大赛伊始,七个小组抽签决定上场顺序。随后,各小组汇报人对PPT的内容进行讲解,主要分为产品简介、产品功能、产品设计、物料计算和产品工艺五个流程。每组汇报人将别具特色的工艺设计和理念充分的展现出来后,两位老师对其存在的问题进行纠正,旨在增强学生们的实践能力、创新能力和合作精神。此次大赛的举办,不仅提升学生们的专业修养,还开拓了学生们的视野,有助于我院培养专业优秀人才。

(十五)“药”点亮生活——第二届药学产品设计及推介大赛
为增强学生专业知识技能的掌握,锻炼学生的自主创新能力,4月28日,我院于医农大教室举行第二届药学产品设计及推介大赛。我院药学专业负责人韩成云及药学教研室教师尹培培、肖道安、闻永举担任评委,21级药学班级全体同学参加比赛。比赛伊始,各小组向评委们展示成果,同时小组代表通过讲解PPT和放映产品的制作过程及广告宣传视频生动地向大家介绍产品的设计理念、成分和功能等。随后评委老师们对各小组进行点评,指出问题所在并提出改进建议。最后,老师们寄语同学们要坚持对自身能力和创新思维的提升。此次大赛的开展,不仅提高同学们的综合素养,还培养了同学们的合作探究能力,进一步丰富我院的创新型教学的内涵,更彰显出我院对专业特色发展的重视。

(十六)微生物艺术大赛
为激发同学们对于微生物的热爱,调动大家的创新积极性,同时培养团队协作能力,4月17日至28日期间,我院在理工楼微生物与免疫实验室举办第一届微生物艺术大赛。本次大赛由我院生物教研室王瑞君、吕美云和刘紫英三位老师担任指导评审老师,21级生物工程班级全体学生参加比赛。


大赛伊始,王瑞君就微生物艺术创作原理进行详细讲解,并强调微生物培养基制作及细菌培养过程中的注意事项。21生物工程班级同学们从历届大赛的优秀作品中获取灵感,理清创作思路,各组队员有序进行固、液培养基的制作,对目的菌株进行扩大培养,在培养皿中绘制出精美微生物的图案。此次比赛的开展,一方面加强了学生们的思维创作和实际动手能力,另一方面也提升了自身对专业知识的了解,为实践创新打下了坚实的基础,也展现出我院团结协作、标新立异的良好学习氛围。

作品主题:梅兰竹菊——无梅花,无霉运。
此次实践周系列活动的开展,一方面展示了同学们的劳动实践内容,巩固专业知识和技能,培养他们的创新意识及动手实践能力;另一方面也展显出我院师生昂扬向上的精神风采,并更加充分展现了我院师生简教与学的成果,为我院后续教学与学生管理工作顺利开展奠定坚实基础。
责编:谢莉莉
审核:陶华蕾